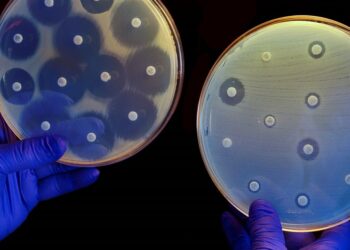
Diseñan una vacuna para combatir la resistencia a los antibióticos

La bombona de butano baja un 3,2 %, el primer recorte en seis meses
El precio máximo de venta al público de la bombona de butano se situará en 16,14 euros a partir de...
Leer másEl lince duplica su población en los últimos tres años y llega a los 2.000 ejemplares
Aunque todavía se encuentra en riesgo de extinción, el lince ibérico avanza en su recuperación. El último censo de 2023...
Leer másUna heladería malagueña reparte helados gratis a pacientes de cáncer en tratamiento de quimioterapia
La heladería La Ibense de Ronda ha puesto en marcha una iniciativa solidaria mediante la cual regalarán helados a personas...
Leer másUn compuesto extraído de la algarroba podría ayudar a tratar enfermedades neurodegenerativas
Un componente de la algarroba, el D-Pinitol (un inositol presente en un extracto natural de algarrobo), podría tener el potencial...
Leer másLa esteponera Ana Mena en la lista Forbes de las mujeres más influyentes de Andalucía
La artista esteponera Ana Mena ha sido elegida por la revista Forbes como una de las 100 las mujeres más...
Leer másUnas gafas de realidad virtual para aliviar la ansiedad de los niños que pasan por el quirófano
El Hospital Santa Ana de Motril ha adquirido gafas de realidad virtual para mejorar la atención que se presta al...
Leer másEspaña entre los países más respetuosos con los derechos LGTBI
España mantiene la cuarta posición en el ranking de países más respetuosos con los derechos LGTBI+, según el Índice Arco...
Leer másEl torremolinense Damián Quintero se proclama subcampeón de Europa de kárate
El torremolinense Damián Quintero se proclamó este fin de semana subcampeón de Europa de kárate en la modalidad de kata...
Leer másDiseñan una vacuna para combatir la resistencia a los antibióticos
Las bacterias resistentes a antibióticos son uno de los grandes problemas de salud pública a los que nos enfrentamos este...
Leer másUna gran ballena azul Sei vuelve a aparece casi 100 años después en la Patagonia
Después de estar desaparecido casi 100 años, un equipo de científicos de la Universidad Nacional de la Patagonia San Juan...
Leer más